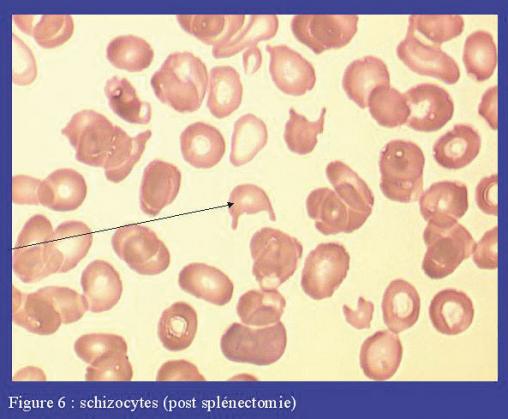

Les schizocytes sont des fragments de globules rouges de formes variées résultant de la cassure de ces globules rouges sur des filaments de fibrine. Les formes en triangle ou en cimier de casque sont les plus typiques. Comme les autres globules rouges pathologiques, les schizocytes sont des cellules fragiles, qui ont tendance à prendre rapidement une forme sphérocytaire, de petite taille. Leur détection est très importante, car elle révèle souvent une anémie hémolytique acquise de cause mécanique. Associée à une thrombopénie, elle permet de porter le diagnostic de microangiopathie thrombotique (purpura thrombotique thrombocytopénique, syndrome hémolytique et urémique…). Chez les patients porteurs de prothèse valvulaire, elle évoque une désinsertion de la prothèse. Les schizocytes se voient également après splénectomie.